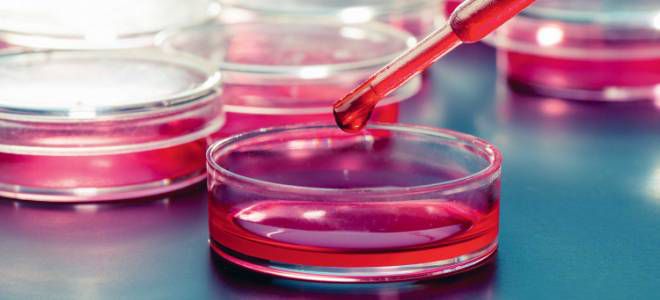
Антифосфолипидный синдром анализ Антифосфолипидный синдром анализ

Антифосфолипидный синдром (АФС) — аутоиммунное заболевание, приводящее к тромбозам, артериальным эмболиям и выкидышам. Важно знать причины, диагностику и клинические рекомендации по лечению, особенно для женщин, планирующих беременность. Эта статья поможет осознать риски, связанные с АФС, и предоставит информацию о современных подходах к его управлению и профилактике осложнений.
АФС-синдром – что это такое?
Примерно 35 лет назад ревматолог Грэм Хьюз выявил патологию, при которой иммунная система начинает производить специфические антитела к фосфолипидам. Эти антитела связываются с тромбоцитами и стенками сосудов, взаимодействуют с белками и участвуют в обменных процессах и свертывании крови. Как первичный, так и вторичный синдром антифосфолипидных антител относятся к аутоиммунным заболеваниям с неясной этиологией. Данная проблема чаще всего затрагивает молодых женщин в репродуктивном возрасте.
Антифосфолипидный синдром представляет собой серьезное заболевание, которое может привести к тромбообразованию и различным осложнениям, включая инсульты и инфаркты. Эксперты подчеркивают, что ранняя диагностика и адекватное лечение играют ключевую роль в управлении этим состоянием. Основные методы борьбы с синдромом включают антикоагулянтную терапию, которая помогает предотвратить образование тромбов, а также регулярный мониторинг состояния пациента. Важно, чтобы пациенты соблюдали рекомендации врачей и проходили регулярные обследования, так как это позволяет снизить риск осложнений. Кроме того, эксперты отмечают необходимость комплексного подхода, включающего изменение образа жизни и контроль сопутствующих заболеваний, что в совокупности способствует улучшению качества жизни пациентов.
https://youtube.com/watch?v=LVpeMqX8dDY
Антифосфолипидный синдром – причины
Ревматологи до сих пор не смогли выяснить, почему возникает данное заболевание. Существуют данные о том, что антифосфолипидный синдром чаще встречается у людей, имеющих родственников с аналогичными проблемами. Кроме наследственного фактора, эксперты выделяют и другие причины, способствующие развитию этой патологии. В таких ситуациях наблюдается вторичный антифосфолипидный синдром, когда выработка антител обусловлена прогрессированием других заболеваний, которые негативно влияют на иммунную систему. Подход к лечению зависит от механизмов, вызывающих заболевание.
| Аспект | Описание | Меры борьбы/Профилактика |
|---|---|---|
| Что такое АФС? | Аутоиммунное заболевание, при котором иммунная система ошибочно атакует собственные белки, связанные с фосфолипидами, что приводит к образованию тромбов. | Ранняя диагностика, регулярное наблюдение у врача. |
| Основные проявления | Тромбозы: венозные (ТЭЛА, тромбоз глубоких вен) и артериальные (инсульты, инфаркты, тромбозы периферических артерий). Акушерские осложнения: повторные выкидыши, преждевременные роды, преэклампсия, задержка внутриутробного развития плода. Другие: тромбоцитопения, кожные проявления (сетчатое ливедо), неврологические нарушения. | Антикоагулянтная терапия (варфарин, НМГ), антиагрегантная терапия (аспирин). |
| Чем грозит? | Инвалидизация (инсульты, ампутации конечностей), летальный исход (массивные тромбозы, ТЭЛА), бесплодие, осложнения беременности. | Строгое соблюдение рекомендаций врача, постоянный контроль МНО при приеме варфарина, регулярные обследования. |
| Диагностика | Клинические критерии (тромбозы, акушерские осложнения) + лабораторные критерии (наличие антифосфолипидных антител: волчаночный антикоагулянт, антитела к кардиолипину, антитела к бета-2-гликопротеину I). | Своевременное обращение к врачу при подозрении на АФС, проведение полного спектра лабораторных анализов. |
| Лечение | Антикоагулянты: для предотвращения образования тромбов (варфарин, низкомолекулярные гепарины). Антиагреганты: для снижения агрегации тромбоцитов (аспирин). При беременности: низкомолекулярные гепарины и низкие дозы аспирина. | Пожизненная терапия в большинстве случаев, индивидуальный подбор дозировок, обучение пациента самоконтролю. |
| Профилактика обострений | Избегание факторов риска тромбозов (курение, ожирение, длительная иммобилизация, прием некоторых гормональных препаратов), контроль сопутствующих заболеваний (гипертония, сахарный диабет). | Здоровый образ жизни, отказ от вредных привычек, регулярные физические нагрузки, консультации с врачом перед приемом новых лекарств. |
| Особенности при беременности | Высокий риск осложнений для матери и плода. Требуется тщательное наблюдение и специализированная терапия. | Планирование беременности под контролем врача, своевременное начало терапии, регулярный мониторинг состояния матери и плода. |
| Прогноз | При своевременной диагностике и адекватном лечении прогноз благоприятный, большинство пациентов ведут полноценную жизнь. Без лечения риск серьезных осложнений высок. | Ответственное отношение к своему здоровью, соблюдение всех предписаний врача. |
Интересные факты
Вот несколько интересных фактов об антифосфолипидном синдроме (АФС):
-
Автоиммунная природа: Антифосфолипидный синдром является автоиммунным заболеванием, при котором иммунная система вырабатывает антитела против фосфолипидов — молекул, важных для нормального функционирования клеточных мембран. Это может привести к тромбообразованию, что увеличивает риск инсультов и инфарктов.
-
Беременность и АФС: Женщины с антифосфолипидным синдромом сталкиваются с повышенным риском осложнений во время беременности, включая выкидыши, преэклампсию и задержку роста плода. Однако при правильном лечении, включая использование антикоагулянтов, многие женщины могут успешно выносить и родить здоровых детей.
-
Диагностика и лечение: Диагностика АФС включает в себя анализ крови на наличие специфических антител, таких как антикардиолипиновые и антикардиолипиновые антитела. Лечение обычно включает антикоагулянты, такие как варфарин или низкомолекулярные гепарины, что помогает снизить риск тромбообразования и улучшить качество жизни пациентов.
https://youtube.com/watch?v=GO7vPh8nI5E
Первичный антифосфолипидный синдром
Данный тип патологии возникает самостоятельно, без связи с другими нарушениями в организме. Лечение синдрома антифосфолипидных антител представляет собой сложную задачу из-за отсутствия явных факторов, способствующих его развитию. Часто первичная форма заболевания проходит практически без симптомов и выявляется лишь на более поздних стадиях прогрессирования или при появлении осложнений.
Вторичный антифосфолипидный синдром
Данный тип аутоиммунной реакции возникает на фоне наличия других системных заболеваний или определенных клинических обстоятельств. Началом патологического процесса, связанного с выработкой антител, может стать даже момент зачатия. Антифосфолипидный синдром у женщин в положении наблюдается в 5% случаев. Если данное заболевание было выявлено ранее, то процесс вынашивания ребенка может значительно ухудшить его течение.
Среди заболеваний, которые могут способствовать развитию антифосфолипидного синдрома, можно выделить:
- вирусные и бактериальные инфекции;
- онкологические опухоли;
- узелковый периартериит;
- системную красную волчанку.
https://youtube.com/watch?v=nxc3bTQg6wA
Антифосфолипидный синдром – симптомы у женщин
Клинические проявления данной патологии отличаются большим разнообразием и отсутствием специфичности, что усложняет процесс дифференциальной диагностики. В некоторых случаях заболевание может протекать бессимптомно, однако чаще всего антифосфолипидный синдром проявляется через рецидивирующие тромбозы как поверхностных, так и глубоких вен и артерий, включая:
- нижние конечности;
- печень;
- сетчатку;
- мозг;
- сердце;
- легкие;
- почки.
Среди наиболее распространенных симптомов у женщин можно выделить:
- выраженный сосудистый рисунок на коже (сетчатое ливедо);
- инфаркт миокарда;
- мигрени;
- удушье;
- боли в грудной клетке;
- варикозное расширение вен;
- тромбофлебит;
- инсульт;
- артериальная гипертензия;
- острая почечная недостаточность;
- асцит;
- ишемические атаки;
- сильный сухой кашель;
- некрозы костей и мягких тканей;
- портальная гипертензия;
- желудочно-кишечные кровотечения;
- тяжелые поражения печени;
- инфаркт селезенки;
- внутриутробная гибель плода;
- самопроизвольный выкидыш.
Антифосфолипидный синдром – диагностика
Подтверждение наличия данной патологии представляет собой сложную задачу, так как она может проявляться под маской других заболеваний и обладает неспецифическими симптомами. Для диагностики этого состояния врачи применяют две группы классификационных критериев. Первоначально обследование на антифосфолипидный синдром начинается с тщательного сбора анамнеза. К первой категории оценочных критериев относятся клинические проявления:
- Тромбоз сосудов. В истории болезни должно быть зафиксировано одно или несколько случаев повреждения вен или артерий, подтвержденных инструментальными и лабораторными методами.
- Акушерская патология. Этот критерий учитывается, если имела место внутриутробная гибель плода после 10-й недели беременности или наблюдались преждевременные роды до 34-й недели, при этом отсутствуют хромосомные, гормональные и анатомические аномалии у родителей.
После сбора анамнеза врач назначает дополнительные исследования. Диагноз антифосфолипидного синдрома ставится при наличии как минимум одного клинического симптома и одного лабораторного критерия. В то же время проводится ряд мероприятий для дифференциальной диагностики. Специалист рекомендует пройти обследования, которые помогут исключить заболевания с похожими проявлениями.
Антифосфолипидный синдром – анализ
Определение лабораторных признаков данного нарушения осуществляется через анализ биологических жидкостей. Врач может назначить анализ крови на антифосфолипидный синдром, чтобы выявить наличие антител к кардиолипинам и волчаночного антикоагулянта в плазме и сыворотке. В дополнение к этому могут быть обнаружены:
- криоглобулины;
- антитела к эритроцитам;
- повышенные уровни Т- и В-лимфоцитов;
- антинуклеарный фактор и ревматоидный фактор.
В некоторых случаях может быть рекомендовано генетическое тестирование, которое позволяет выявить маркеры антифосфолипидного синдрома:
- HLA-DR7;
- HLA-B8;
- HLA-DR2;
- DR3-HLA.
Как лечить антифосфолипидный синдром?
Лечение данного аутоиммунного заболевания зависит от его типа (первичный или вторичный) и степени проявления клинических симптомов. Проблемы возникают, когда у беременной женщины диагностируется антифосфолипидный синдром – терапия должна эффективно устранять симптомы болезни, предотвращать тромбообразование и одновременно быть безопасной для плода. Для достижения устойчивых результатов врачи-ревматологи применяют комбинированный подход в терапии.
Можно ли вылечить антифосфолипидный синдром?
Невозможно полностью устранить описанную проблему, пока не будут выявлены причины ее появления. При антифосфолипидном синдроме необходимо использовать комплексный подход к лечению, который сосредоточен на снижении уровня соответствующих антител в крови и предотвращении тромбоэмболических осложнений. В случаях тяжелого течения заболевания требуется применение противовоспалительной терапии.
Лечение антифосфолипидного синдрома – современные рекомендации
Основным методом борьбы с проявлениями данной патологии является применение антиагрегантов и антикоагулянтов непрямого действия:
- ацетилсалициловая кислота (Аспирин и его аналоги);
- Варфарин;
- Аценокумарол;
- Фенилин;
- Дипиридамол.
Рекомендации по лечению антифосфолипидного синдрома:
- Избегать курения, употребления алкоголя и наркотиков, а также оральных контрацептивов.
- Изменить рацион, добавив продукты, богатые витамином К, такие как зеленый чай, печень и листовые зеленые овощи.
- Обеспечить полноценный отдых и придерживаться режима дня.
Если стандартные методы лечения не приносят результатов, могут быть назначены дополнительные препараты:
- аминохинолины – Плаквенил, Делагил;
- прямые антикоагулянты – Клексан, Фраксипарин;
- глюкокортикоиды – Преднизолон, Метилпреднизолон;
- ингибиторы тромбоцитарных рецепторов – Тагрен, Клопидогрель;
- гепариноиды – Эмеран, Сулодексид;
- цитостатики – Эндоксан, Цитоксан;
- иммуноглобулины (внутривенное введение).
Народная медицина при антифосфолипидном синдроме
Действенных альтернативных методов лечения не существует, и единственным вариантом остается замена ацетилсалициловой кислоты на натуральные компоненты. Антифосфолипидный синдром невозможно устранить с помощью народных средств, так как природные антикоагулянты действуют слишком мягко. Прежде чем использовать любые альтернативные методы, необходимо проконсультироваться с ревматологом. Только квалифицированный специалист сможет помочь в облегчении состояния при антифосфолипидном синдроме, и рекомендации врача следует строго придерживаться.
Чай с эффектом аспирина
Ингредиенты:
- сухая кора белой ивы – 1-2 ч. ложки;
- кипяток – 180-220 мл.
Приготовление и применение:
- Тщательно промойте и измельчите растительное сырье.
- Заварите кору ивы кипятком и дайте настояться 20-25 минут.
- Употребляйте полученный раствор как чай 3-4 раза в день, при желании можно добавить немного сахара.
Антифосфолипидный синдром – прогноз
Все пациенты, страдающие от заболеваний, связанных с антифосфолипидным синдромом, должны находиться под постоянным наблюдением и регулярно проходить профилактические осмотры. Продолжительность жизни с данным синдромом зависит от его типа, степени тяжести и наличия сопутствующих иммунных нарушений. В случае первичного антифосфолипидного синдрома с умеренной симптоматикой, адекватная терапия и профилактическое лечение могут значительно снизить риск осложнений, что в свою очередь создает благоприятный прогноз.
Однако наличие таких заболеваний, как системная красная волчанка, тромбоцитопения, стойкая артериальная гипертензия и другие патологии, может усугубить ситуацию. В таких случаях часто возникает антифосфолипидный сложный синдром (катастрофический), который проявляется нарастанием клинических симптомов и повторяющимися тромбозами. Некоторые из этих последствий могут привести к летальному исходу.
Антифосфолипидный синдром и беременность
Данное заболевание является одной из основных причин невынашивания беременности, поэтому всем будущим матерям рекомендуется проходить профилактические обследования и сдавать анализы на коагулограмму. Антифосфолипидный синдром в акушерской практике представляет собой серьезный фактор, способствующий выкидышам и гибели плода, однако его наличие не является окончательным приговором. Женщина с таким диагнозом может успешно выносить и родить здорового ребенка, если во время беременности будет следовать всем рекомендациям врача и принимать антиагреганты.
Аналогичный подход применяется и в случае планирования искусственного оплодотворения. Антифосфолипидный синдром и ЭКО могут сосуществовать, но перед этим необходимо пройти курс противотромботических препаратов. Применение антикоагулянтов и антиагрегантов будет продолжаться на протяжении всей беременности. Эффективность такого лечения близка к 100%.
Профилактика антифосфолипидного синдрома
Профилактика антифосфолипидного синдрома (АФС) является важным аспектом управления этим заболеванием, так как оно может привести к серьезным осложнениям, таким как тромбообразование и выкидыши. Основные меры профилактики направлены на снижение риска тромбообразования и поддержание общего здоровья пациента.
Во-первых, важно проводить регулярные медицинские обследования и мониторинг состояния здоровья. Люди с диагнозом АФС должны находиться под наблюдением врача-ревматолога или гематолога, который сможет контролировать уровень антител и оценивать риск тромбообразования. Это особенно актуально для женщин, планирующих беременность, так как АФС может значительно увеличить риск осложнений во время беременности.
Во-вторых, изменение образа жизни играет ключевую роль в профилактике АФС. Рекомендуется следить за своим весом, так как избыточная масса тела может увеличить риск тромбообразования. Регулярные физические нагрузки, такие как прогулки, плавание или занятия спортом, помогут поддерживать нормальный вес и улучшить общее состояние здоровья. Также важно избегать длительного сидения или стояния, особенно в условиях, когда это может привести к застою крови.
Третьим важным аспектом является контроль за уровнем холестерина и артериального давления. Питание должно быть сбалансированным и включать в себя достаточное количество фруктов, овощей, цельнозерновых продуктов и полезных жиров, таких как омега-3 жирные кислоты. Ограничение потребления насыщенных жиров и сахара также поможет снизить риск сердечно-сосудистых заболеваний.
Кроме того, для профилактики тромбообразования могут быть назначены антикоагулянты, такие как аспирин или более сильные препараты, в зависимости от индивидуальных показателей риска. Важно строго следовать рекомендациям врача и не заниматься самолечением, так как неправильное применение антикоагулянтов может привести к серьезным последствиям.
Наконец, важно учитывать психологический аспект. Стресс и эмоциональное напряжение могут негативно сказаться на состоянии здоровья, поэтому рекомендуется практиковать методы релаксации, такие как йога, медитация или дыхательные упражнения. Поддержка со стороны семьи и друзей также играет важную роль в эмоциональном благополучии пациента с АФС.
Таким образом, профилактика антифосфолипидного синдрома включает в себя комплексный подход, который сочетает в себе медицинское наблюдение, изменение образа жизни, контроль за сопутствующими заболеваниями и психологическую поддержку. Это позволит значительно снизить риск осложнений и улучшить качество жизни пациентов.
Вопрос-ответ
Сколько живут с антифосфолипидным синдромом?
С соблюдением адекватной медикаментозной терапии большая часть пациентов с АФС имеет благоприятный прогноз выживаемости при сохранном качестве жизни. По данным крупных европейских исследований десятилетняя выживаемость пациентов с ПАФС составляет 90-94%.
Чем опасен антифосфолипидный синдром?
Антифосфолипидный синдром приводит к инфаркту миокарда, причём известно, что чаще это случается с мужчинами. А вот у женщин он провоцирует головные боли и инсульт. В период беременности антифосфолипидный синдром часто прогрессирует, что может вызывать самопроизвольные выкидыши.
Какова ожидаемая продолжительность жизни человека с антифосфолипидным синдромом?
Какова ожидаемая продолжительность жизни человека с антифосфолипидным синдромом? АФС обычно не влияет на продолжительность жизни. Он может вызвать смертельные осложнения, если образуется тромб, блокирующий кровеносный сосуд в одном из органов, особенно если у вас хронический антифосфолипидный синдром.
Как вылечить антифосфолипидный синдром?
Реабилитация. Антифосфолипидный синдром – это неизлечимое заболевание. Полностью избавиться от него невозможно. Реабилитация заключается в стабилизации состояния организма, общеукрепляющих мероприятиях.
Советы
СОВЕТ №1
Регулярно проходите медицинские обследования. Если у вас есть предрасположенность к антифосфолипидному синдрому, важно регулярно проверять уровень антител и следить за состоянием здоровья. Это поможет выявить проблему на ранней стадии и начать лечение.
СОВЕТ №2
Обратите внимание на образ жизни. Здоровое питание, регулярные физические нагрузки и отказ от вредных привычек могут значительно снизить риск тромбообразования. Убедитесь, что ваш рацион богат витаминами и минералами, особенно витаминами группы B и омега-3 жирными кислотами.
СОВЕТ №3
Консультируйтесь с врачом по поводу медикаментозного лечения. Если у вас уже диагностирован антифосфолипидный синдром, важно следовать рекомендациям врача и принимать назначенные препараты, такие как антикоагулянты, для снижения риска тромбообразования.
СОВЕТ №4
Общайтесь с другими людьми, страдающими от антифосфолипидного синдрома. Поддержка и обмен опытом с теми, кто сталкивается с аналогичными проблемами, могут помочь вам лучше справляться с заболеванием и находить новые способы борьбы с ним.